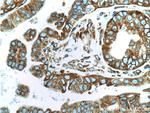
RPS3 Antibody in Immunohistochemistry (Paraffin) (IHC (P))
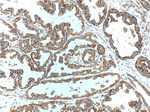
RPS3 Antibody in Immunohistochemistry (Paraffin) (IHC (P))

Search
Proteintech
RPS3 Monoclonal Antibody (2G7H4)
{{$productOrderCtrl.translations['antibody.pdp.commerceCard.promotion.promotions']}}
{{$productOrderCtrl.translations['antibody.pdp.commerceCard.promotion.viewpromo']}}
{{$productOrderCtrl.translations['antibody.pdp.commerceCard.promotion.promocode']}}: {{promo.promoCode}} {{promo.promoTitle}} {{promo.promoDescription}}. {{$productOrderCtrl.translations['antibody.pdp.commerceCard.promotion.learnmore']}}
产品信息
66046-1-IG
种属反应
已发表种属
宿主/亚型
分类
类型
克隆号
抗原
偶联物
形式
浓度
规格
纯化类型
保存液
内含物
保存条件
运输条件
产品详细信息
Immunogen sequence: MAVQISKKR KFVADGIFKA ELNEFLTREL AEDGYSGVEV RVTPTRTEII ILATRTQNVL GEKGRRIREL TAVVQKRFGF PEGSVELYAE KVATRGLCAI AQAESLRYKL LGGLAVRRAC YGVLRFIMES GAKGCEVVVS GKLRGQRAKS MKFVDGLMIH SGDPVNYYVD TAVRHVLLRQ GVLGIKVKIM LPWDPTGKIG PKKPLPDHVS IVEPKDEILP TTPISEQKGG KPEPPAMPQP VPTA (1-243 aa encoded by BC003137)
靶标信息
WD repeat domain 5 (WDR5) is a member of the WD repeat protein family, which is involved in a variety of cellular processes, including cell cycle progression, signal transduction, apoptosis, and gene regulation. WDR5, also known as BIG-3, is expressed in the developing growth plate, accelerates chondrocyte and osteoblast differentiation in vitro, and regulates osteoblast differentiation during embryonic bone development. WDR5 interacts with the pluripotency factor Oct4/POU5F1 and is required for the efficient formation of induced pluripotent stem (iPS) cells.
仅用于科研。不用于诊断过程。未经明确授权不得转售。
生物信息学
蛋白别名: 40S ribosomal protein S3; FLJ26283; FLJ27450; IMR-90 ribosomal protein S3; MGC87870; OTTHUMP00000229804; OTTHUMP00000229805; OTTHUMP00000229874; OTTHUMP00000229877; OTTHUMP00000229878; OTTHUMP00000229879; OTTHUMP00000229880; OTTHUMP00000229882; OTTHUMP00000229883; OTTHUMP00000229886; Small ribosomal subunit protein uS3; unnamed protein product
基因别名: D7Ertd795e; OK/SW-cl.26; RPS3; Rs_3; S3; uS3
UniProt ID: (Human) P23396, (Mouse) P62908, (Rat) P17073
Entrez Gene ID: (Human) 6188, (Mouse) 27050, (Rat) 140654